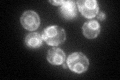
YJR088C
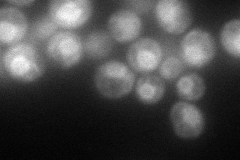
YJR088C
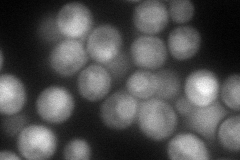
YJR088C
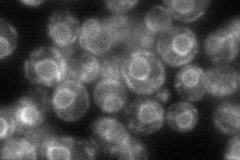
YJR088C
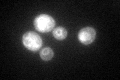
YJR088C
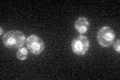
YJR088C

View description
Member of a transmembrane complex required for efficient folding of proteins in the ER; null mutant displays induction of the unfolded protein response
Localization:
Intensity:
Fold change:
Significance:
-
C’ GFP library in SD
ER69.53 -
N' NOP1pr-GFP in SD
ER130.916 -
N' TEF2pr-mCherry in SD
nuclear periphery112.645 -
N' NATIVEpr-GFP in SD
ER64.6828 -
N' TEF2pr-VC and Cyto-VN in SD

cytosol33.1743 -
C’ GFP library in SD+DTT
ER72.211.03No -
C’ GFP library in SD+H2O2

ER60.780.87No -
C’ GFP library in Starvation Media
ER61.690.88No -
C’ GFP library on the background of Pup2-DaMP

ER -
C’ GFP library on the background of CCT mutant

ER83.97041.20744No
